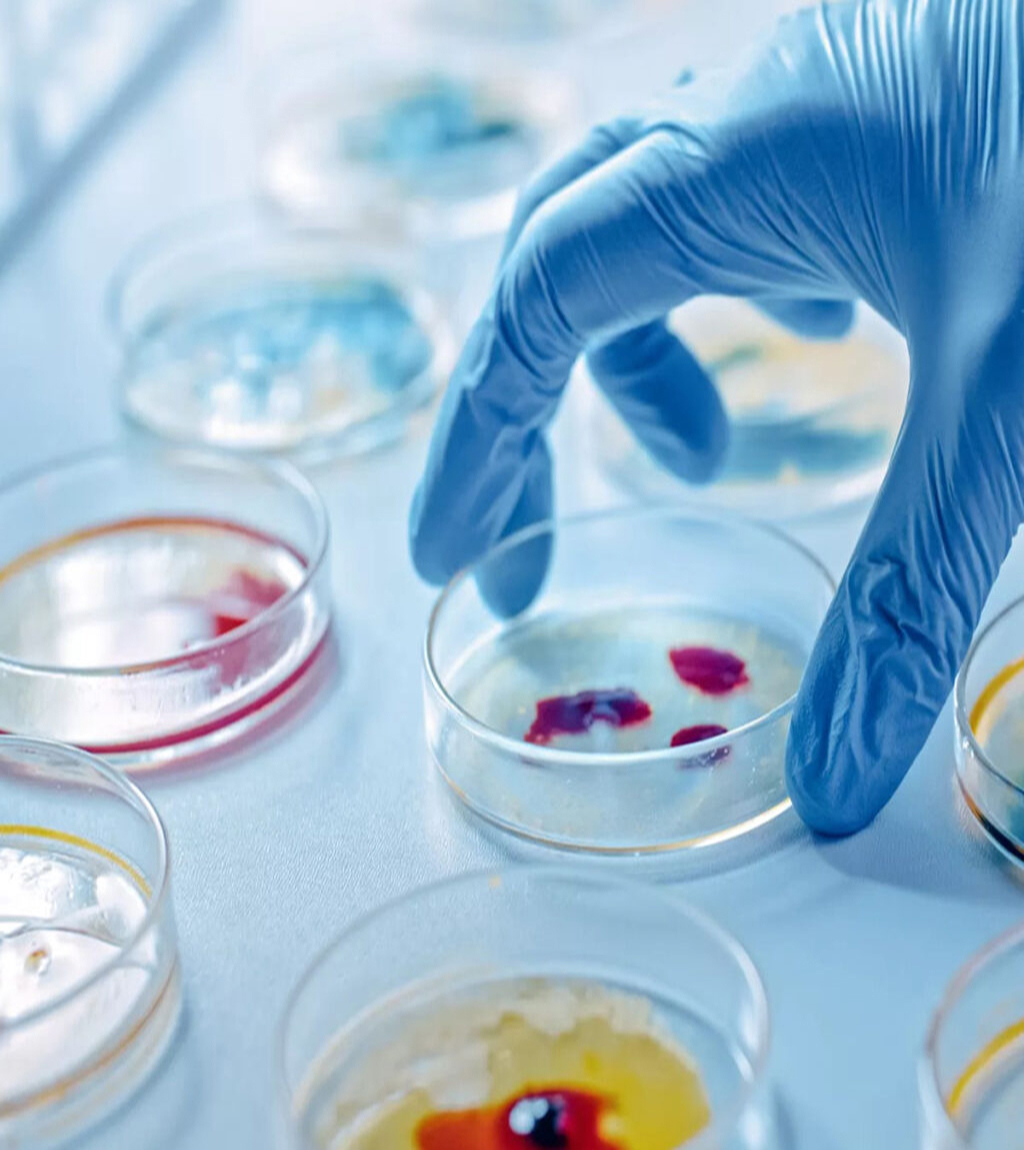

Our Commitment:
The Microbiology Diagnostic Laboratory at UH-KDU is dedicated to upholding the highest standards in clinical microbiology, contributing to a safer hospital environment and enhanced patient outcomes through:
- Rigorous quality control and assurance
- Evidence-based diagnostic support
- Collaborative partnerships with clinical, IPC, and public health team
About Us
The Department of Microbiology at UH KDU offers essential bacteriology-based diagnostic services to support clinical decision-making and hospital infection prevention efforts. Our focus is on delivering accurate, timely, and clinically relevant results that contribute directly to the quality and safety of patient care.
Laboratory Standards and Quality Assurance:
- Adherence to national and international laboratory standards, including:
- Clinical and Laboratory Standards Institute (CLSI) guidelines for antimicrobial susceptibility testing and interpretation
- Good Laboratory Practices (GLP) in specimen handling, media preparation, and reporting
- Standard Operating Procedures (SOPs) developed by the Sri Lanka Collge of Microbiologists.
- Compliance with biosafety level 2 (BSL-2) practices in handling clinical specimens
- Internal Quality Assurance (IQA):
- Regular quality control of media, reagents, and equipment
- Periodic audits of laboratory processes and documentation
- Staff competency assessments and routine refresher training
- External Quality Assurance (EQA):
- Active participation in Ministry of Health (Sri Lanka) EQA program conducted by Medical research Institute
Services Offered
- Routine bacteriological culture, identification, and antimicrobial susceptibility testing (AST) using standard methods
- Critical result reporting to ensure prompt clinical intervention and improved patient outcomes
- Outsourcing of specialized tests (e.g., mycology, virology, TB, molecular diagnostics) to accredited national reference laboratories
- Operating theatre air quality monitoring, including periodic active and passive air sampling in accordance with regulatory standards
- Environmental sampling and surveillance
- Outbreak support and epidemiological investigations through laboratory confirmation
- Data sharing with the Infection Prevention and Control (IPC) team for monitoring trends and alerting on multidrug-resistant organisms (MDROs)
- Participation in hospital antimicrobial stewardship programs, guiding rational antibiotic use through laboratory evidence

Our Team

Dr. Dilini Nakkawita

Dr. Alge Wattege Tharindu Sandaruwan

Mrs. R. Vinoda Madushani Ranasundara

Mrs. Shalini Dias

Mr. PASL Wijesuriya

Mr. FPM Deluxan

Dr.Dilini Nakkawita
(MBBS(Colombo), PG.Dip.Micro(Colombo), MD(Colombo), Dip.RCPath(UK)) Consultant Microbiologist & Senior Lecturer

Dr. Alge Wattege Tharindu Sandaruwan
MBBS(KDU) Pdip Infect Dis (RCPI), Msc Infect Dis (Cand.) LSHTM Medical Officer in Microbiology, UHKDU

Mrs. R. Vinoda Madushani Ranasundara
BSc.(Hons) in Medical Laboratory Sciences, General Sir John Kotelawala Defense University In-charge Medical Laboratory Technologist, Microbiology Lab, UHKDU

Mrs. Shalini Dias
BSc.(Hons) in Medical Laboratory Science, General Sir John Kotelawala Defense University Medical Laboratory Technologist, Microbiology Lab, UHKDU

P. A. S. L. Wijesuriya
B.Sc (Hons) in Medical Laboratory Science, University of Peradeniya Medical Laboratory Technologist,Microbiology Lab, UHKDU

F.P.M.Deluxan
BSc. (Hons) in Medical laboratory Sciences (University of Jaffna) Medical Laboratory Technologist in Diagnostic Laboratory, Microbiology Lab, UHKDU
Contact Department of Microbiology
Email Us
microbiology_lab@kdu.ac.lk
Call Us
011 2044555 – Extension: 4178